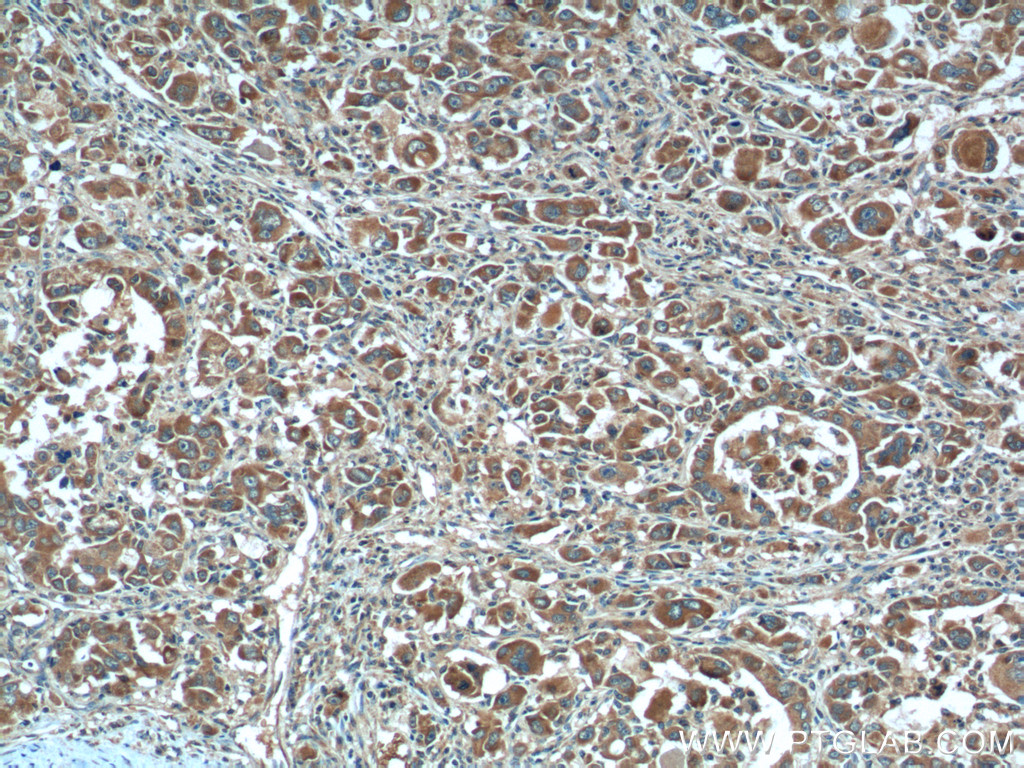

验证数据展示
经过测试的应用
| Positive WB detected in | HEK-293T cells, MCF-7 cells, mouse liver tissue, rat liver tissue |
| Positive IHC detected in | human breast cancer tissue, human colon cancer tissue, human liver cancer tissue, mouse liver tissue Note: suggested antigen retrieval with TE buffer pH 9.0; (*) Alternatively, antigen retrieval may be performed with citrate buffer pH 6.0 |
| Positive FC (Intra) detected in | HepG2 cells |
推荐稀释比
| 应用 | 推荐稀释比 |
|---|---|
| Western Blot (WB) | WB : 1:1000-1:6000 |
| Immunohistochemistry (IHC) | IHC : 1:50-1:500 |
| Flow Cytometry (FC) (INTRA) | FC (INTRA) : 0.40 ug per 10^6 cells in a 100 µl suspension |
| It is recommended that this reagent should be titrated in each testing system to obtain optimal results. | |
| Sample-dependent, Check data in validation data gallery. | |
产品信息
24868-1-AP targets XBP1S-specific in WB, IHC, IF, FC (Intra), ELISA applications and shows reactivity with human, mouse, rat samples.
| 经测试应用 | WB, IHC, FC (Intra), ELISA Application Description |
| 文献引用应用 | WB, IHC, IF |
| 经测试反应性 | human, mouse, rat |
| 文献引用反应性 | human, mouse, rat, pig, monkey, bovine, hamster |
| 免疫原 |
CatNo: Ag21703 Product name: Recombinant human XBP1 protein Source: e coli.-derived, PGEX-4T Tag: GST Domain: 167-376 aa of BC000938 Sequence: GAGPVVTPPEHLPMDSGGIDSSDSESDILLGILDNLDPVMFFKCPSPEPASLEELPEVYPEGPSSLPASLSLSVGTSSAKLEAINELIRFDHIYTKPLVLEIPSETESQANVVVKIEEAPLSPSENDHPEFIVSVKEEPVEDDLVPELGISNLLSSSHCPKPSSCLLDAYSDCGYGGSLSPFSDMSSLLGVNHSWEDTFANELFPQLISV 种属同源性预测 |
| 宿主/亚型 | Rabbit / IgG |
| 抗体类别 | Polyclonal |
| 产品类型 | Antibody |
| 全称 | X-box binding protein 1 |
| 别名 | XBP1, Tax-responsive element-binding protein 5, TREB-5, X box binding protein 1, X-box-binding protein 1 |
| 计算分子量 | 261 aa, 29 kDa |
| 观测分子量 | 45-65 kDa |
| GenBank蛋白编号 | BC000938 |
| 基因名称 | XBP1 |
| Gene ID (NCBI) | 7494 |
| RRID | AB_2879766 |
| 偶联类型 | Unconjugated |
| 形式 | Liquid |
| 纯化方式 | Antigen affinity purification |
| UNIPROT ID | P17861 |
| 储存缓冲液 | PBS with 0.02% sodium azide and 50% glycerol, pH 7.3. |
| 储存条件 | Store at -20°C. Stable for one year after shipment. Aliquoting is unnecessary for -20oC storage. |
背景介绍
XBP1, also named as XBP2, belongs to the bZIP family. The X-box-binding protein-1 (XBP1) is a transcriptional regulator of the ER stress response that lies downstream of inositol-requiring enzyme 1 (IRE1α) activation (PMID: 14559994). XBP1 localizes in the nucleus. As a transcription factor, it is essential for hepatocyte growth, the differentiation of plasma cells, the immunoglobulin secretion, and the unfolded protein response. XBP1 has an association with major affective disorder. The unspliced XBP1U isoform is composed of 261 amino acid residues, and the spliced XBP1S isoform is composed of 376 amino acid residues. The calculated molecular weight of protein generated from the unspliced XBP1 isoform XBP1U mRNA is 33 kDa, and protein generated from spliced XBP1 isoform XBP1S mRNA is 40 kDa, and shows at 45-65 kDa range. This antibody specially recognizes the XBP1S isoform.
实验方案
| Product Specific Protocols | |
|---|---|
| FC protocol for XBP1S-specific antibody 24868-1-AP | Download protocol |
| IHC protocol for XBP1S-specific antibody 24868-1-AP | Download protocol |
| WB protocol for XBP1S-specific antibody 24868-1-AP | Download protocol |
| Standard Protocols | |
|---|---|
| Click here to view our Standard Protocols |
发表文章
| Species | Application | Title |
|---|---|---|
Nat Commun A nanoemulsion targeting adipose hypertrophy and hyperplasia shows anti-obesity efficiency in female mice | ||
Acta Pharm Sin B The substitution of SERCA2 redox cysteine 674 promotes pulmonary vascular remodeling by activating IRE1α/XBP1s pathway. | ||
Nat Commun Activation of GCN2/ATF4 signals in amygdalar PKC-δ neurons promotes WAT browning under leucine deprivation. | ||
Cancer Lett LIMK1 m6A-RNA methylation recognized by YTHDC2 induces 5-FU chemoresistance in colorectal cancer via endoplasmic reticulum stress and stress granule formation | ||
Diabetes Lipid Droplets Protect Human β-Cells From Lipotoxicity-Induced Stress and Cell Identity Changes. | ||
Oxid Med Cell Longev Drp1-Mediated Mitochondrial Metabolic Dysfunction Inhibits the Tumor Growth of Pituitary Adenomas. |